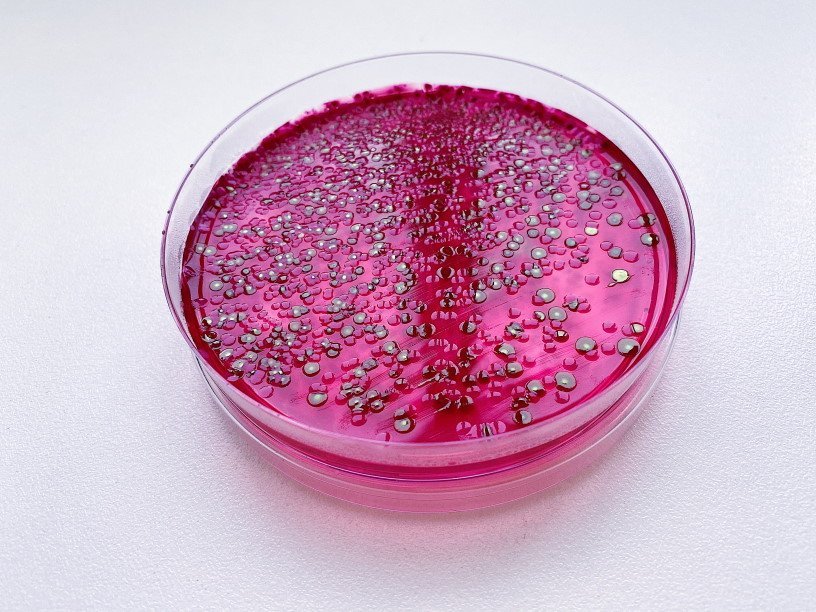

Екатерина Беленко: Промикробы: Чувство локтя
Промикробы: Чувство локтя Фото: Екатерина Беленко Бактерии умеют удивлять! Такие малюсенькие и достаточно примитивные создания преподносят иногда сюрпризы, одним из которых стало чувство кворума. Чувство кворума — широко распространенный в природе механизм, позволяющий группам организмов выполнять координированные, слаженные действия — подобно тому, как это постоянно делают клетки многоклеточного организма. Но в многоклеточном организме слаженность поведения клеток обеспечивается специальными системами централизованного управления — нервной и гуморальной. В группе же отдельных самостоятельных организмов таких централизованных систем управления нет. У одноклеточных организмов, в том числе у бактерий, согласованное групповое поведение основано на своеобразном химическом «голосовании». Например, все бактерии в популяции «вбрасывают» сигнальное вещество, и когда концентрация этого вещества в окружающей среде достигает некого порогового значения, все клетки дружно меняют свое поведение.
⠀
Назначение чувства кворума — координировать определенное поведение или действия между бактериями того же вида или подвида в зависимости от плотности их населения. Например, оппортунистические патогенные бактерии Pseudomonas aeruginosa (она же синегнойная палочка, я вам про нее рассказывала) могут размножаться в пределах хозяина без ущерба для последнего, пока они не достигают определённой концентрации. Но они становятся агрессивными, когда их число становится достаточным, чтобы преодолеть иммунную систему хозяина, приводя к развитию болезни. Для того чтобы сделать это, бактериям необходимо сформировать биопленки (про них мы тоже не так давно говорили) на поверхности тела хозяина.
⠀
Возможно, что терапевтическая ферментативная деградация сигнальных молекул предотвращает образование таких биопленок. Проще говоря, необходимо подобрать такой фермент, который разрушит молекулу-сигнал. Тогда информация не дойдет до адресата, а без биопленки гораздо проще избавиться от незваных гостей организма. Разрушение сигнального процесса таким образом — подавление чувства кворума. Ещё один плюс такого метода заключается в том, что этот фермент-разрушитель попутно не будет наносить вред «доброй» микрофлоре или повышать устойчивость к антимикробным препаратам.
⠀
У разных видов бактерий различные процессы регулируются чувством кворума. Так, если у синегнойки это развитие опасных биопленок и агрегация клеток, то у кишечной палочки — процесс деления клеток. E. coli не надеется ни на какие лужайки, а регулирует «рождаемость» в зависимости от плотности бактериального населения. А, например, Streptococcus pneumoniae (он же пневмококк) использует чувство кворума, чтобы сделать клетки компетентными. Это может быть важным для увеличения количества мутаций в условиях перенаселения, когда возникает необходимость колонизации новых окружений.
Смотрите также: Екатерина Беленко Промикробы: Волшебная палочка Екатерина Беленко Промикробы: Скрытые фигуры Екатерина Беленко Промикробы: Плесень и липовый мёд Екатерина Беленко Промикробы: Кровь и пептон Максим Руссо Опасные для человека бактерии, устойчивые к антибиотикам